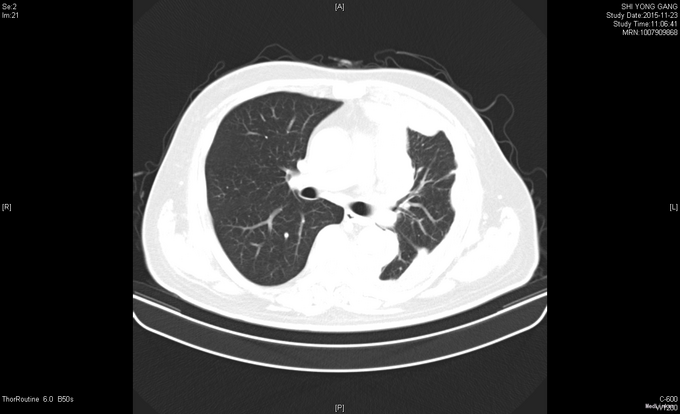

恶性胸膜间皮瘤一例
主诉 病史
患者于2015年2月中旬无明显诱因出现咳嗽咳痰,中等量白色粘痰,无痰中带血,至当地卫生院予以消炎治疗(具体不详),症状无明显好转。出现胸闷气喘,平卧时加重,无粉红色泡沫痰,无发热,无咯血,至XX医院就诊,查胸部X线提示左侧大量胸腔积液。胸部及上腹部增强CT提示左肺上叶条索灶,左侧胸膜明显不均匀增厚,间皮瘤?转移?左侧胸腔积液,左下肺膨胀不全,肝右叶后段小类圆形稍低密度影,囊肿?胆囊壁增厚。右肾囊肿。腹膜后小淋巴结。2015-03-17 B超引导下行胸膜活检术,术后病理示(左侧胸膜穿刺)镜下见少量异型细胞,免疫组化结果:CK7(++),NapsinA(-),TTF-1(-),CK20(-),Villin(-),Ki-67(<2%+),CK(+),MC(+),结合HE切片、临床表现及影像学资料,符合恶性间皮瘤。头颅MRI未见异常。ECT全身骨显像未见异常。患者拒绝化疗等治疗后出院。后患者症状持续存在,遂于2015-07-21至XX医院就诊,排除禁忌,于2015-07-22予以化疗(培美曲塞二钠1g d1+顺铂40mg d1-3)1周期。并于2015年8月开始间断予以DC+CIK细胞免疫治疗。
查体 辅查
查体:左下肺呼吸音低,余查体未见明显异常。 辅查:血常规、血生化等未见明显异常;肿瘤标志物:CA125 846.80IU/ml↑、CA15-3 101.60IU/mL↑、细胞角蛋白19片段(Cyfra21-1)5.25ng/ml↑ 胸部CT示:1、左侧胸膜间皮瘤治疗后,局部心包受侵可能,心包少量积液;2、左肺高密度灶,炎症可能,淋巴管转移待排;3、左侧胸腔少量积液左肺膨胀不全;4、纵隔多发稍增大淋巴结。腹部CT示:1、腹膜后多发稍大淋巴结;2、脾脏肿大;3、右肾多发囊肿;4、左侧胸膜不规则增厚,恶性病变可能,请结合临床;心包少量积液。头颅MRI、骨骼ECT未见明显异常。

诊断 处理
诊治经过:入院后完善相关检验检查,结合病史及外院胸膜活检病理结果,考虑患者恶性胸膜间皮瘤诊断明确,排除有关禁忌症后,于11-01起行AP方案化疗:AP:培美曲塞 1g d1+顺铂 130mg d1,化疗后无特殊不良反应,经请示上级医师同意后予办理出院。
随访 讨论
讨论:对恶性胸膜间皮瘤尚未有效的治疗方法,国内外均有少数病人活过5年,大多数人认为可能与肿瘤自然生存时间和分期有关。按Butchart分期,恶性胸膜间皮瘤分为四期。根据临床表现,Ⅰ期上皮型恶性胸膜间皮瘤有可能长期生存,故建议为这些病人作根治性胸膜肺切除术。对Ⅱ、Ⅲ和Ⅳ期上皮型及其他病理类型的病例,无论治与不治,采用根治性或姑息性手术及使用化疗和放疗疗效与否,治疗后的生存曲线基本相同,其平均生存时间为18个月,约10%病例活过了3年。
